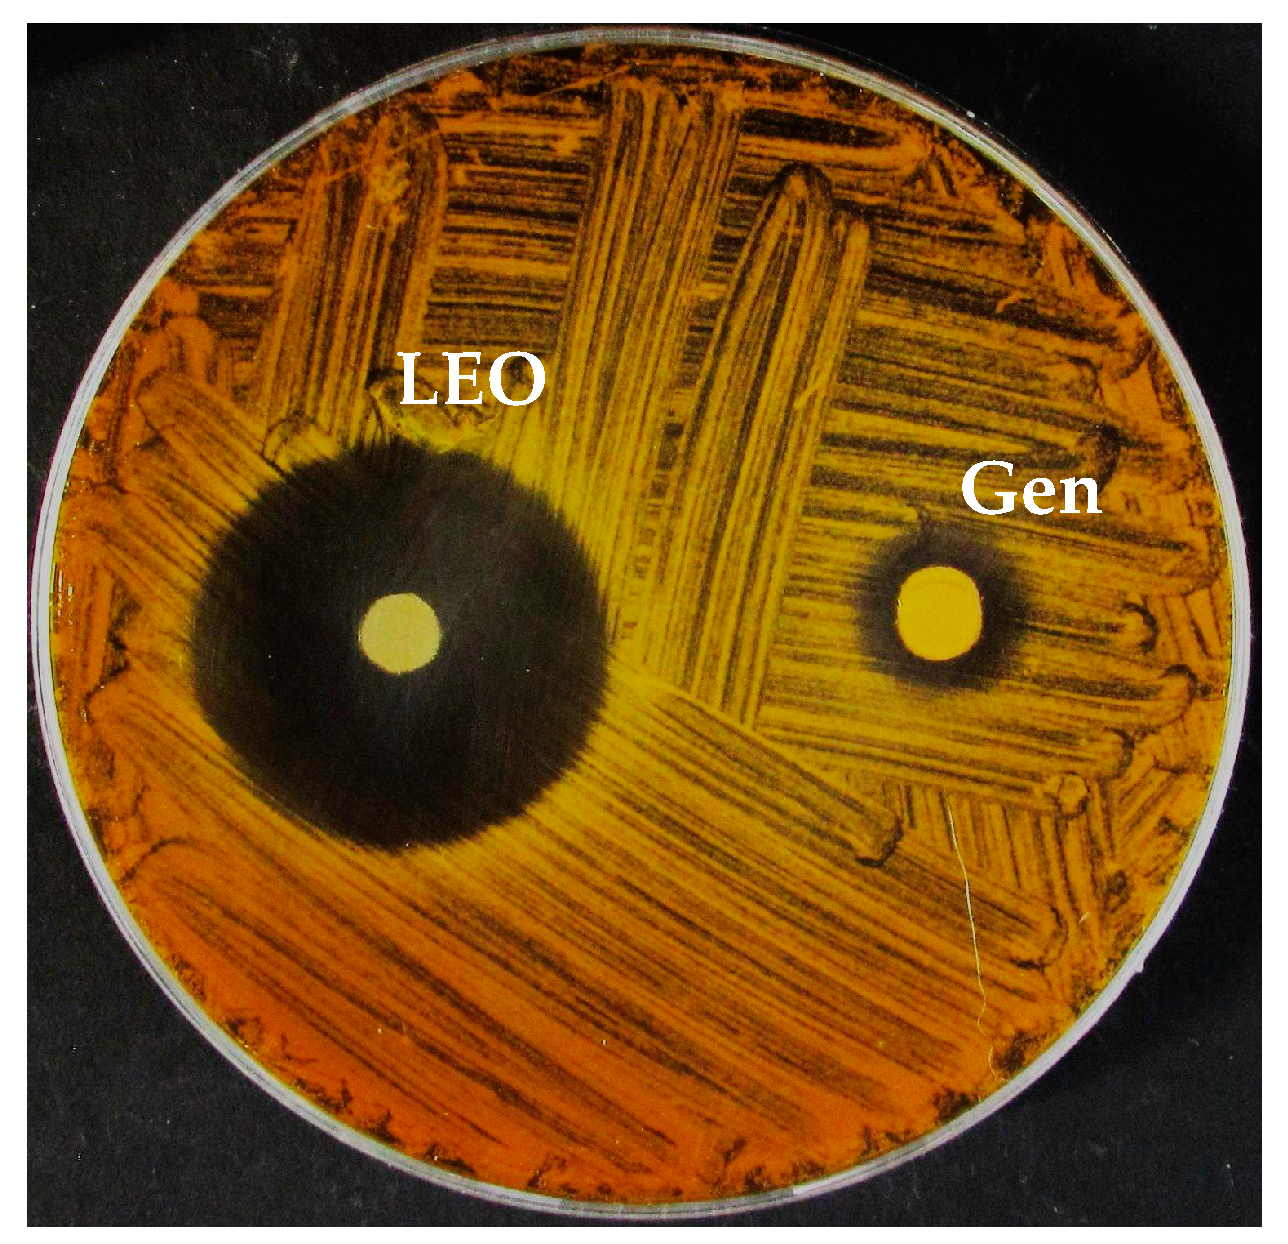
Molecules 24 02701 g001 Molecules 24 02701 g001

Liquid and Vapour Phase of Lavandin (Lavandula × intermedia) Essential Oil: Chemical Composition and Antimicrobial Activity
Abstract
1. Introduction
2. Results
2.1. LEO Chemical Composition
2.2. LEO Antibacterial Activity—Agar Diffusion Method
2.3. Minimum Inhibitory Concentration (MIC)
2.4. Minimum Bactericidal Concentration (MBC)
2.5. Vapour Phase Test (VPT)
3. Discussion
4. Materials and Methods
4.1. Plant Materials
4.2. Gas Chromatography–Mass Spectrometry (GC–MS) Analysis
4.3. Headspace GC–MS Analysis
4.4. Microorganisms Tested and Growth Conditions
4.5. Agar Diffusion Method
4.6. Minimum Inhibitory Concentration (MIC)
4.7. Minimum Bactericidal Concentration (MBC)
4.8. Vapour Phase Test (VPT)
4.9. Statistical Analysis
5. Conclusions
Author Contributions
Funding
Acknowledgments
Conflicts of Interest
References
- Bozin, B.; Mimica-Dukic, N.; Simin, N.; Anackov, G. Characterization of the volatile composition of essential oils of some lamiaceae spices and the antimicrobial and antioxidant activities of the entire oils. J. Agric. Food Chem. 2006, 54, 1822–1828. [Google Scholar] [CrossRef] [PubMed]
- Nikolić, M.; Jovanović, K.K.; Marković, T.; Marković, D.; Gligorijević, N.; Radulović, S.; Soković, M. Chemical composition, antimicrobial, and cytotoxic properties of five Lamiaceae essential oils. Ind. Crop. Prod. 2014, 61, 225–232. [Google Scholar] [CrossRef]
- Mamadalieva, N.Z.; Akramov, D.K.; Ovidi, E.; Tiezzi, A.; Nahar, L.; Azimova, S.S.; Sarker, S.D. Aromatic Medicinal Plants of the Lamiaceae Family from Uzbekistan: Ethnopharmacology, Essential Oils Composition, and Biological Activities. Medicines 2017, 4, 8. [Google Scholar] [CrossRef] [PubMed]
- Malcolm, B.J.; Tallian, K. Essential oil of lavender in anxiety disorders: Ready for prime time? Ment. Health Clin. 2018, 7, 147–155. [Google Scholar] [CrossRef] [PubMed]
- Nieto, G. Biological Activities of Three Essential Oils of the Lamiaceae Family. Medicines 2017, 4, 63. [Google Scholar] [CrossRef] [PubMed]
- Tanrikulu, G.İ.; Ertürk, Ö.; Yavuz, C.; Can, Z.; Çakir, H.E. Chemical compositions, antioxidant and antimicrobial activities of the essential oil and extracts of Lamiaceae Family (Ocimum basilicum and Thymbra spicata) from Turkey. Int. J. Sec. Metabol. 2017, 4, 340–348. [Google Scholar] [CrossRef]
- Upson, T. The taxonomy of the genus. In Lavender: The Genus Lavandula; Lis-Balchin, M., Ed.; Taylor & Francis Inc.: London, UK, 2002; Volume 2, pp. 2–34. [Google Scholar]
- Gols, R. Direct and indirect chemical defences against insects in a multitrophic framework. Plant Cell Environ. 2014, 37, 1741–1752. [Google Scholar] [CrossRef] [PubMed]
- Sharifi-Rad, J.; Sureda, A.; Tenore, G.; Daglia, M.; Sharifi-Rad, M.; Valussi, M.; Tundis, R.; Sharifi-Rad, M.; Loizzo, M.R.; Ademiluyi, A.O.; et al. Biological Activities of Essential Oils: From Plant Chemoecology to Traditional Healing Systems. Molecules 2017, 22, 70. [Google Scholar] [CrossRef]
- Baser, K.H.C.; Buchbauer, G. Handbook of Essential Oils. Science, Technology, and Applications, 2nd ed; CRC Press: Boca Raton, FL, USA, 2015. [Google Scholar] [CrossRef]
- Gautam, N.; Mantha, A.K.; Mittal, S. Essential oils and their constituents as anticancer agents: A mechanistic view. BioMed Res. Int. 2014, 2014, 154106. [Google Scholar] [CrossRef]
- Dhifi, W.; Bellili, S.; Jazi, S.; Bahloul, N.; Mnif, W. Essential Oils’ Chemical Characterization and Investigation of Some Biological Activities: A Critical Review. Medicines 2016, 3, 25. [Google Scholar] [CrossRef]
- Elshafie, H.S.; Camele, I. An overview of The Biological Effects of Some Mediterranean Essential Oils on Human Health. BioMed Res. Int. 2017, 2017, 9268468. [Google Scholar] [CrossRef]
- Hajhashemi, V.; Ghannadi, A.; Sharif, B. Anti-inflammatory and analgesic properties of the leaf extracts and essential oil of Lavandula angustifolia Mill. J. Ethnopharmacol. 2003, 89, 67–71. [Google Scholar] [CrossRef]
- Miguel, M.G. Antioxidant and Anti-Inflammatory Activities of Essential Oils: A short review. Molecules 2010, 15, 9252–9287. [Google Scholar] [CrossRef]
- Schuwald, A.M.; Nöldner, M.; Wilmes, T.; Klugbauer, N.; Leuner, K.; Müller, W.E. Lavender oil-potent anxiolytic properties via modulating voltage dependent calcium channels. PLoS ONE 2013, 8, e59998. [Google Scholar] [CrossRef]
- Poyton, C.; Manchadi, M.L.; Cheesman, M.; Lavidis, N. Effects of Lavender and Linalool on Neurotransmission and Contraction of Smooth Muscle. Pharmacogn. Commun. 2015, 5, 217–225. [Google Scholar] [CrossRef]
- Donadu, M.G.; Usai, D.; Mazzarello, V.; Molicotti, P.; Cannas, S.; Bellardi, M.G.; Zanetti, S. Change in Caco-2 cells following treatment with various lavender essential oils. Nat. Prod. Res. 2017, 31, 2203–2206. [Google Scholar] [CrossRef]
- Cardia, G.F.E.; Silva-Filho, S.E.; Silva, E.L. Effect of Lavender (Lavandula angustifolia) Essential Oil on Acute Inflammatory Response. Evid-Based Complement. Altern. 2018, 2018, 1413940. [Google Scholar] [CrossRef]
- Moon, T.; Wilkinson, J.M.; Cavanagh, H.M. Antiparasitic activity of two Lavandula essential oils against Giardia duodenalis, Trichomonas vaginalis and Hexamita inflata. Parasitol. Res. 2006, 99, 722–728. [Google Scholar] [CrossRef]
- Mori, H.M.; Kawanami, H.; Kawahata, H.; Aoki, M. Wound healing potential of lavender oil by acceleration of granulation and wound contraction through induction of TGF-β in a rat model. BMC Complement. Altern. Med. 2016, 16, 144. [Google Scholar] [CrossRef]
- Lis-Balchin, M.; Hart, S. Studies on the mode of action of the essential oil of lavender (Lavandula angustifolia P. Miller). Phytother. Res. 1999, 13, 540–542. [Google Scholar] [CrossRef]
- Rota, C.; Carraminana, J.J.; Burillo, J.; Herrera, A. In vitro antimicrobial activity of essential oils from aromatic plants against selected foodborne pathogens. J. Food. Prot. 2004, 67, 1252–1256. [Google Scholar] [CrossRef]
- Soković, M.; Marin, P.D.; Brkć, D.; Van Griensven, L.J.L.D. Chemical composition and antibacterial activity of essential oils of ten aromatic plants against human pathogenic bacteria. Food 2007, 1, 220–226. [Google Scholar]
- Martucci, J.F.; Gende, L.B.; Neira, L.M.; Ruseckaite, R.A. Oregano and lavender essential oils as antioxidant and antimicrobial additives of biogenic gelatin films. Ind. Crops Prod. 2015, 71, 205–213. [Google Scholar] [CrossRef]
- Smigielski, K.; Prusinowska, R.; Stobiecka, A.; Kunicka-Styczyñska, A.; Gruska, R. Biological Properties and Chemical Composition of Essential Oils from Flowers and Aerial Parts of Lavender (Lavandula angustifolia). J. Essent. Oil Bear. Plants 2018, 21, 1303–1314. [Google Scholar] [CrossRef]
- Park, C.H.; Park, Y.E.; Yeo, H.J.; Chun, S.W.; Baskar, T.B.; Lim, S.S.; Park, S.U. Chemical Compositions of the Volatile Oils and Antibacterial Screening of Solvent Extract from Downy Lavender. Foods 2019, 8, 132. [Google Scholar] [CrossRef]
- Tardugno, R.; Serio, A.; Pellati, F.; D’Amato, S.; Chaves López, C.; Bellardi, M.G.; Di Vito, M.; Savini, V.; Paparella, A.; Benvenuti, S. Lavandula x intermedia and Lavandula angustifolia essential oils: Phytochemical composition and antimicrobial activity against foodborne pathogens. Nat. Prod. Res. 2018, 21, 1–6. [Google Scholar] [CrossRef]
- Lesage-Meessen, L.; Bou, M.; Sigoillot, J.C.; Faulds, C.B.; Lomascolo, A. Essential oils and distilled straws of lavender and lavandin:a review of current use and potential application in white biotechnology. Appl. Microbiol. Biotechnol. 2015, 99, 3375–3385. [Google Scholar] [CrossRef]
- Ghelardini, C.; Galeotti, N.; Salvatore, G.; Mazzanti, G. Local anaesthetic activity of the essential oil of Lavandula angustifolia. Planta Med. 1999, 67, 564–566. [Google Scholar] [CrossRef]
- Caputo, L.; Souza, L.F.; Alloisio, S.; Cornara, L.; De Feo, V. Coriandrum sativum and Lavandula angustifolia Essential Oils: Chemical Composition and Activity on Central Nervous System. Int. J. Mol. Sci. 2016, 17, 1999. [Google Scholar] [CrossRef]
- Bajalan, I.; Rouzbahani, R.; Pirbalouti, A.G.; Maggi, F. Chemical Composition and Antibacterial Activity of Iranian Lavandula × hybrida. Chem. Biodivers. 2017, 14, e1700064. [Google Scholar] [CrossRef]
- Jianu, C.; Pop, G.; Gruia, A.T.; Horhat, F.G. Chemical composition and antimicrobial activity of essential oils of lavender (Lavandula angustifolia) and lavandin (Lavandula x intermedia) grown in Western Romania. Int. J. Agric. Biol. 2013, 15, 772–776. [Google Scholar]
- Verma, R.S.; Rahman, L.U.; Chanotiya, C.S.; Verma, R.K.; Chauhan, A.; Yadav, A.; Singh, A.; Yadav, A.K. Essential oil composition of Lavandula angustifolia Mill. cultivated in the mid hills of Uttarakhand, India. J. Serbian Chem. Soc. 2010, 75, 343–348. [Google Scholar] [CrossRef]
- Peracino, V.; Caramiello, R.; Maffei, M. Essential oils from same Lavandula hybrids growing spontaneously in North West Italy. Flavour Fragr. J. 1994, 9, 11–17. [Google Scholar] [CrossRef]
- Pistelli, L.; Giovanelli, N.S.; Lorenzini, L.; Tavarini, S.; Angelini, L.G. Agronomic and phytochemical evaluation of lavandin and lavender cultivars cultivated in the Tyrrhenian area of Tuscany (Italy). Ind. Crop Prod. 2017, 109, 37–44. [Google Scholar] [CrossRef]
- Garzoli, S.; Laghezza Masci, V.; Turchetti, G.; Pesci, L.; Tiezzi, A.; Ovidi, E. Chemical investigations of male and female leaf extracts from Schinus molle L. Nat. Prod. Res. 2019, 33, 1980–1983. [Google Scholar] [CrossRef]
- Oliva, A.; Costantini, S.; De Angelis, M.; Garzoli, S.; Bozovic, M.; Mascellino, M.T.; Vullo, V.; Ragno, R. High potency of Maleleuca Alternifolia essential oil against multi-drug resistent Gram-negative bacteria and methicillin–resistant Staphyloccocus aureus. Molecules 2018, 23, 2584. [Google Scholar] [CrossRef]
- Oliva, A.; Garzoli, S.; Sabatino, M.; Andreotti, E.; Tadic, V.; Costantini, S.; Ragno, R.; Bozovic, M. Chemical composition and antimicrobial activity of essential oil of Helichrysum italicum (Roth) G. Don fil. (Asteraceae) from Montenegro. Nat. Prod. Res 2019. [Google Scholar] [CrossRef]
- Balouiri, M.; Sadiki, M.; Ibnsouda, S.A. Methods for in vitro evaluating antimicrobial activity: A review. J. Pharm. Biomed. Anal. 2016, 6, 71–79. [Google Scholar] [CrossRef]
- Clinical and Laboratory Standards Institute. M23–A3: Development of In Vitro Susceptibility Testing Criteria and Quality Control Parameters; Approved Guideline, 3rd ed.; CLSI Document; Clinical and Laboratory Standards Institute: Wayne, PA, USA, 2008; Volume 28. [Google Scholar]
- Lopez, P.; Sanchez, C.; Battle, R.; Nerin, C. Solid-and Vapor-Phase Antimicrobial Activities of Six Essential Oils : Susceptibility of Selected Foodborne Bacterial and Fungal Strains. J. Agric. Food Chem. 2005, 53, 6939–6946. [Google Scholar] [CrossRef]
- Nedorostova, L.; Kloucek, P.; Kokoska, L.; Stolcova, M.; Pulkrabek, J. Antimicrobial properties of selected essential oils in vapour phase against foodborne bacteria. Food Control 2009, 20, 157–160. [Google Scholar] [CrossRef]
- Tyagi, A.K.; Malik, A. Morphostructural Damage in Food-Spoiling Bacteria due to the Lemon Grass Oil and Its Vapour : SEM, TEM, and AFM Investigations. Evid. Based Complement. Altern. Med. 2012, 2012, 692625. [Google Scholar] [CrossRef]
Sample Availability: LEO sample is available from the authors. |
| No. | Component 1 | LRIlit 2 | LRI 3 | LRI 4 | GC Peak Area (%) | HS-GC Peak Area (%) |
|---|---|---|---|---|---|---|
| 1 | α-pinene | 1021 | 1019 | 935 | 1.1 | 8.7 |
| 2 | camphene | 1065 | 1055 | 946 | 0.5 | 3.7 |
| 3 | β-pinene | 1105 | 1100 | 981 | 0.4 | 2.8 |
| 4 | myrcene | 1156 | 1152 | 984 | 1.5 | 4.9 |
| 5 | α-phellandrene | 1160 | 1161 | 999 | 0.1 | 0.7 |
| 6 | limonene | 1198 | 1195 | 1025 | 1.0 | 3.5 |
| 7 | 1,8-cineole | 1209 | 1210 | 1028 | 5.2 | 19.8 |
| 8 | (Z)-β-ocimene | 1237 | 1231 | 1038 | 0.9 | - |
| 9 | γ-terpinene | 1241 | 1235 | 1046 | 0.2 | - |
| 10 | trans-β-ocimene | 1276 | 1275 | 1055 | 0.7 | - |
| 11 | terpinolene | 1282 | 1283 | 1072 | 0.4 | - |
| 12 | o-cymene | 1287 | 1290 | 1025 | 0.2 | 1.7 |
| 13 | hexyl isobutyrate | 1335 | 1333 | 1145 | 0.3 | - |
| 14 | 1-octen-3-yl-acetate | 1401.9 | 1400 | 1122 | 0.5 | 0.7 |
| 15 | hexyl butanoate | 1410 | 1414 | 1177 | 0.5 | - |
| 16 | 1-octen-3-ol | 1458 | 1461 | 970 | 0.3 | 0.4 |
| 17 | camphor | 1507 | 1500 | 1133 | 6.0 | 4.4 |
| 18 | linalool | 1537 | 1539 | 1092 | 41.6 | 35.8 |
| 19 | linalyl acetate | 1553 | 1549 | 1245 | 23.0 | 7.5 |
| 20 | lavandulyl acetate | 1584 | 1580 | 1265 | 3.2 | 0.8 |
| 21 | terpinen-4-ol | 1603 | 1600 | 1174 | 4.8 | 2.9 |
| 22 | (E)-β-caryophyllene | 1613 | 1615 | 1428 | 1.3 | - |
| 23 | (Z)-β-farnesene | 1630 | 1635 | 1445 | 1.3 | - |
| 24 | α-terpineol | 1675 | 1680 | 1185 | 1.6 | 0.4 |
| 25 | γ-muurolene | 1685 | 1687 | 1508 | 0.5 | - |
| 26 | borneol | 1717 | 1721 | 1158 | 2.8 | 1.2 |
| Total (%) | 99.9 | 99.9 | ||||
| Monoterpenoids | 89.2 | 94.4 | ||||
| Sesquiterpenoids | 3.1 | - | ||||
| Others | 7.6 | 5.5 |
| Component | EPh | Lavandin |
|---|---|---|
| linalool | 25–45 | 41.6 |
| linalyl acetate | 25–46 | 23.0 |
| 1,8-cineole | max. 2.5 | 5.2 |
| camphor | 12–18 | 6.0 |
| Agar Diffusion Test | LEO (10 µL) | Gen (20 µg) | |
|---|---|---|---|
| Strain | halo ± SD (mm) | halo ± SD (mm) | |
| Gram− | Escherichia coli | 13.0 ± 1.41 | 16.5 ± 2.12 |
| Acinetobacter bohemicus | 47.0 ± 4.24 | 34.5 ± 0.70 | |
| Pseudomonas fluorescens | 8.5 ± 0.70 | 25.5 ± 0.70 | |
| Gram+ | Bacillus cereus | 21.5 ± 0.70 | 28.5 ± 0.70 |
| Kocuria marina | 14.5 ± 2.12 | 27.0 ± 2.83 |
| Microdilution Test | LEO | Gen | |||
|---|---|---|---|---|---|
| Strain | MIC (%Mean) | MBC (%Mean) | MIC (µg/mLMean) | MBC (µg/mLMean) | |
| Gram− | E. coli | 1.87 | 1.87 | 3.12 | 6.25 |
| A. bohemicus | 0.47 | 0.47 | 0.08 | 0.31 | |
| P. fluorescens | 3.75 | 7.51 | 1.56 | 6.25 | |
| Gram+ | B. cereus | 0.94 | Bacteriostatic | 1.56 | 3.12 |
| K. marina | 1.87 | Bacteriostatic | 0.39 | 1.56 | |
| LEO VPT (Vapour Phase Test) | |||
|---|---|---|---|
| Strain | MIC (µL Mean) | * MBC (µL Mean) | |
| Gram− | E. coli | 20 | 40 |
| A. bohemicus | <2 | 20 | |
| P. fluorescens | >40 | >40 | |
| Gram+ | B. cereus | 20 | 20 |
| K. marina | 20 | 40 | |
© 2019 by the authors. Licensee MDPI, Basel, Switzerland. This article is an open access article distributed under the terms and conditions of the Creative Commons Attribution (CC BY) license (http://creativecommons.org/licenses/by/4.0/).
Share and Cite
Garzoli, S.; Turchetti, G.; Giacomello, P.; Tiezzi, A.; Laghezza Masci, V.; Ovidi, E. Liquid and Vapour Phase of Lavandin (Lavandula × intermedia) Essential Oil: Chemical Composition and Antimicrobial Activity. Molecules 2019, 24, 2701. https://doi.org/10.3390/molecules24152701
Garzoli S, Turchetti G, Giacomello P, Tiezzi A, Laghezza Masci V, Ovidi E. Liquid and Vapour Phase of Lavandin (Lavandula × intermedia) Essential Oil: Chemical Composition and Antimicrobial Activity. Molecules. 2019; 24(15):2701. https://doi.org/10.3390/molecules24152701
Chicago/Turabian StyleGarzoli, Stefania, Giovanni Turchetti, Pierluigi Giacomello, Antonio Tiezzi, Valentina Laghezza Masci, and Elisa Ovidi. 2019. "Liquid and Vapour Phase of Lavandin (Lavandula × intermedia) Essential Oil: Chemical Composition and Antimicrobial Activity" Molecules 24, no. 15: 2701. https://doi.org/10.3390/molecules24152701
APA StyleGarzoli, S., Turchetti, G., Giacomello, P., Tiezzi, A., Laghezza Masci, V., & Ovidi, E. (2019). Liquid and Vapour Phase of Lavandin (Lavandula × intermedia) Essential Oil: Chemical Composition and Antimicrobial Activity. Molecules, 24(15), 2701. https://doi.org/10.3390/molecules24152701

